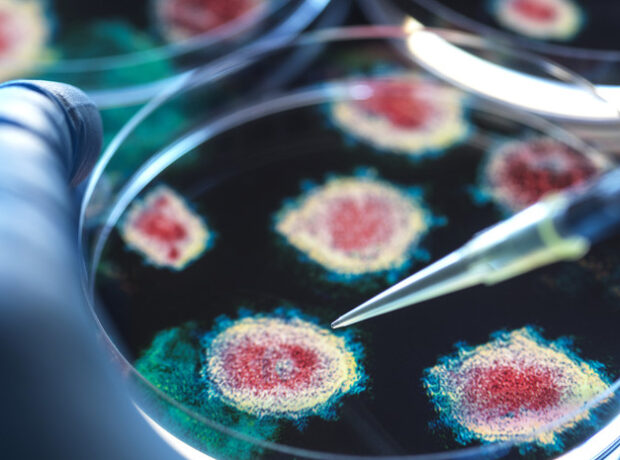
image-6911f94bae5ac92496548af0

Sinqapurlu tədqiqatçılar müəyyən ediblər ki, çox zaman sadəcə soyuqdəymə ilə səhv salınan tənəffüs sinsitial virusu (RSV) şiddət və sağlamlığa uzunmüddətli təsirləri baxımından qrip və koronavirus (COVID-19) qədər təhlükəlidir.
Doğru.az xəbər verir ki, Sinqapur Ümumi Xəstəxanasının mətbuat xidmətinin məlumatına görə, üç böyük kohort tədqiqatının nəticələri göstərib: RSV səbəbilə xəstəxanaya yerləşdirilən xəstələrdə ürək və digər uzunmüddətli ağırlaşmaların riski qrip və COVID-19 halları ilə eynidir.
Ümumilikdə 13 minə yaxın xəstə üzərində aparılan təhlil göstərib ki, RSV-yə yoluxan hər 20 xəstədən biri (5%) həyatını itirir. Beləliklə, bu virusdan ölüm göstəricisi qripdən daha yüksək, xəstəliyin ağırlıq dərəcəsi isə COVID-19 ilə müqayisə edilə biləcək səviyyədədir.
Həmçinin, RSV səbəbilə xəstəxanaya yerləşdirilən hər onuncu (10%) insanda ürək-damar problemləri aşkarlanıb ki, bu da koronavirusdan daha çoxdur.
Tədqiqatçılar bildiriblər ki, RSV-yə yoluxmuş yetkin xəstələrdə xəstəxanaya düşdükdən sonra 300 gün ərzində ürək-damar və nevroloji ağırlaşmaların riski yüksək olaraq qalır. Uşaqlarda isə bu virus qrip və COVID-19 ilə müqayisədə tənəffüs yollarının ağırlaşmalarına daha çox səbəb olur.
Qeyd edək ki, immunoloq və tibb elmləri namizədi Nikolay Kryuçkov daha əvvəl uzun sürən soyuqdəymə hallarını “bir neçə respirator virusun qarışığı” adlandırmışdı.
DOĞRU.AZ